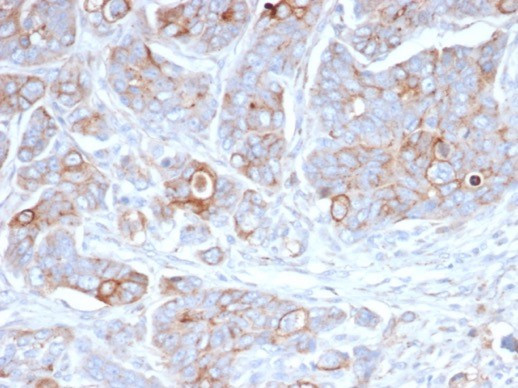
CD138/Syndecan-1 (SDC1) (Plasma Cell Marker) Antibody in Immunohistochemistry (Paraffin) (IHC (P))

Search
NeoBiotechnologies
CD138/Syndecan-1 (SDC1) (Plasma Cell Marker) Monoclonal Antibody (SDC1/7178)
{{$productOrderCtrl.translations['antibody.pdp.commerceCard.promotion.promotions']}}
{{$productOrderCtrl.translations['antibody.pdp.commerceCard.promotion.viewpromo']}}
{{$productOrderCtrl.translations['antibody.pdp.commerceCard.promotion.promocode']}}: {{promo.promoCode}} {{promo.promoTitle}} {{promo.promoDescription}}. {{$productOrderCtrl.translations['antibody.pdp.commerceCard.promotion.learnmore']}}
产品信息
6382-MSM8-P1ABX
种属反应
宿主/亚型
分类
类型
克隆号
抗原
偶联物
形式
浓度
纯化类型
保存液
内含物
保存条件
运输条件
靶标信息
CD138 (syndecan 1) is a transmembrane proteoglycan that can bind a variety of cytokines and modulate their activity, as well as the activity of extracellular matrix components and influence many developmental processes. CD138 is expressed mainly in differentiating keratinocytes and is transiently upregulated in all layers of the epidermis upon tissue injury. It is also highly expressed on plasma cells and can be detected even on fibroblasts, vascular smooth muscle cells and endothelial cells. Up-regulation and down-regulation of CD138 on the cell surface often correlates with the gain of cancerous characteristics. Serum levels of the shedded soluble sCD138 are used as a prognostic factor of cancerogenesis.
仅用于科研。不用于诊断过程。未经明确授权不得转售。
篇参考文献 (0)
生物信息学
蛋白别名: CD antigen 138; CD138; CD138 antigen; heparan sulfate proteoglycan fibroblast growth factor receptor; sCD138; soluble CD138; SYND1; syndecan proteoglycan 1; Syndecan-1; Syndecan1
基因别名: CD138; SDC; SDC1; SYND1; syndecan
UniProt ID: (Human) P18827
Entrez Gene ID: (Human) 6382